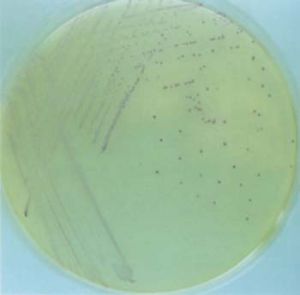
新生兒敗血症

病因
沙門菌
沙門菌致病菌隨著抗生素的套用不斷發生變化,歐美國家40年代以A組溶血性鏈球菌占優勢,50年代以金黃色葡萄球菌為主,60年代以大腸桿菌占優勢,70年代以後B組溶血性鏈球菌(GBS)成為最多見的細菌,大腸桿菌次之,克雷白桿菌、綠膿桿菌、沙門菌也頗重要。近年來表皮葡萄球菌成為美國醫院內獲得性感染最常見的細菌。中國仍以大腸桿菌(多具有K1抗原)和金黃色葡萄球菌最常見,克雷白桿菌、綠膿桿菌和L細菌(以Lister研究所定名)感染常有報導,表皮葡萄球菌感染不斷增加,GBS雖有報導但不多。以上細菌在產前或產後發生感染,但以產後為主,產後感染多從新生兒皮膚損傷、臍帶污染、口腔、呼吸道或消化道黏膜侵入。
敗血征可以由於母親感染所致,在分娩前如果母親有發燒,細菌感染,細菌可以通過羊水感染胎兒,胎膜早破、產程延長、羊水渾濁發臭、新生兒皮膚破損、臍炎等都提示有造成新生兒敗血征的可能性。
症狀
一、臨床表現
 新生兒敗血症
新生兒敗血症足月兒和晚期新生兒(生後2~4周)臨床症狀有發熱、拒食、神萎或煩躁不安,早產兒和低出生體重兒症狀不典型,表現為拒奶、溢奶、不哭、不動、面色蒼白、體重不增、體溫不穩、有時體溫不升。
除上列症狀外,下列表現提示有敗血症可能。①黃疸加重或減退後又復現。有時黃疸可能是本症的主要表現。②肝脾輕度或中度腫大,無其他原因可解釋。③瘀點或瘀斑不能以新生兒紫癜或外傷解釋。嚴重敗血症可出現中毒性腸麻痹,表現為腹脹,腸鳴音減低。或發生瀰漫性血管內凝血、嘔血、便血,或肺出血。
歐美國家常見的B組溶血性鏈球菌(GBS)敗血症,中國也有報導。美國孕婦陰道和直腸GBS帶菌率高達20%~35%,出生的嬰兒生後3天內約有40%~75%帶同型細菌,但發病的僅1~2%。GBS敗血症分早發和晚發兩型,早髮型感染來自宮內或產時,GBSⅠa、Ⅰb、Ⅰc、ⅡⅢ各型都可能是病因。主要累及肺臟。嬰兒在生後0~4天發病,臨床表現和肺部X線片與新生兒肺透明膜病相似,甚至病理改變也相仿。晚髮型感染多來自醫護人員,90%由GBSⅢ型引起,起病多在出生5天后,約80%並發化膿性腦膜炎。
患敗血征時可表現為精神食慾差,哭聲弱,體溫不穩定,可發燒,也可表現為體溫不升。隨著病情進展孩子開始不吃奶、不會哭、面色發灰,精神萎靡,愛睡覺。此外還常出現黃疸加重或原已消退後又再次出現黃疸,遇此情況應懷疑本症。隨著病情進展還可出現肝脾腫大、皮膚出血點和瘀斑,甚至瀰漫性血管內凝血。嚴重者可有休克表現,面色倉白,皮膚出現大理石樣花紋,脈搏細而快,四肢發軟,少尿或無尿。敗血征還可出現合併症,如中毒性腸麻痹、化膿性關節炎、骨髓炎、腦膜炎等。
二、診斷
1.病史凡有以下危險因素均要考慮細菌感染的可能:①羊膜早破大於12~24h;②母孕後期有發熱和絨毛膜炎病史;③出生時Apgar評分低並有搶救史;④早產、雙胎。
院內感染易發生於下列情況:①新生兒監護病區(NICU)治療的患兒;②有入侵式治療的患兒如氣管插管、臍靜脈插管等;③住院天數長;④接受手術治療的患兒;⑤病房擁擠;⑥長期套用廣譜抗生素治療等。
2.臨床表現新生兒常表現為非特異性的症狀。
 呼吸窘迫
呼吸窘迫(2)心率增快和周圍循環灌注差,青紫。
(3)低血壓。
(5)體溫不穩定:10%~30%的新生兒可有發熱和體溫不升。
(6)胃腸道症狀:包括嘔吐、腹瀉、腹脹、納差。
(7)活動減弱或嗜睡、煩躁不安、呻吟。
(8)抽痙。
(9)瘀斑或瘀點。
3.實驗室檢查
(1)外周血白細胞計數和分類血白細胞計數0.2提示有細菌感染。
(2)血小板計數血小板計數15μg/ml提示有細菌感染,②ESR>15mm/h。
(4)血培養檢查血培養陽性可確立病因診斷,疑有感染的患兒均需在入院後用抗菌素前取周圍血做培養,並應嚴格遵守無菌操作,防止污染。如患兒用過作用於細胞壁的抗生素,如青黴素、頭孢菌素,可用高滲培養基作L型細菌培養,懷疑有厭氧菌感染時,可作厭氧菌培養。
(5)其他部位培養臍部、尿液、大便或其他局部感染灶的培養。
(6)放射學的檢查胸部X線檢查在有呼吸系統症狀的患兒均應進行。
(7)病原菌抗原檢測如對流免疫電泳、乳膠凝集試驗,血凝抑制試驗等方法。
檢查
1.周圍血白細胞計數高低不一,也可正常,因此意義不大,但桿狀核白細胞與中性粒細胞之比≥0.2有參考價值。2.培養最好在用抗生素前作血培養,皮膚消毒和操作必須嚴格無菌,以免培養出污染菌。如已用過青黴素或頭孢黴素治療可用高滲培養基作L型細菌培養。遷移性病灶的膿液培養如陽性,有很大診斷意義。
3.快速診斷可選用酶聯免疫吸附法。
4.直接塗片找細菌如疑有宮內感染,於出生後1小時內取外耳道內液體或胃液作塗片找細菌,若陽性表示宮內羊水被污染,但小嬰兒不一定發病。
治療
 抗生素
抗生素(1)大腸桿菌敗血症 一般認為脂膜早破,產程延長,產時感染以及生後3d內發病的以大腸桿菌感染為主,可選用氨苄青黴素加用慶大黴素或丁胺卡那黴素。氨苄青黴素為新生兒期細菌感染的常用藥物,不僅對球菌具有強大的抗菌作用,對新生兒感染常見病原菌如大腸桿菌、流感桿菌等革蘭陰性桿菌具有較高的抗菌活性。劑量:日齡≤7d,用50mg/(kg·d)分2次靜脈滴注;日齡>7d,用75mg/(kg·d),分三次靜脈給藥。慶大黴素劑量:2500g:5mg/(kg·d)分為每8hl次。由於慶大黴素有耳毒副作用,使用時應作血藥濃度的監測。因大腸桿菌各菌株的藥敏差別較大,應以藥敏試驗結合臨床選用抗生素。對上述抗生素耐藥或臨床療效不佳,可改用第三代頭孢菌素。第三代頭孢菌素治療各種革蘭陰性和陽性需氧菌所致的敗血症療效滿意。尤其是對革蘭陰性細菌,療效更為突出,有效率達84%~97%。如頭孢氨噻肟和頭孢三嗪除有明顯的殺菌作用外,還能透過有炎症的血腦屏障。上述二種頭孢菌素的劑量:頭孢氨噻肟:日齡:7d:150mg/(kg·d)分3次靜脈給藥。頭孢三嗪:50mg/(kg·d)分1~2次靜脈套用。治療的療程為2~3周左右。
(2)金黃色葡萄球菌敗血症 新生兒皮膚、黏膜有化膿性感染,以及醫院出生且住院較長者常常以金葡菌感染為主。治療可選用青黴素,但金黃色葡萄球菌大多數對青黴素耐藥,故常用耐酸青黴素,如苯唑青黴素、鄰氯青黴素、雙氯青黴素,或用萬古黴素加上述耐酶青黴素。上述3種耐酶青黴素的劑量:7d100mg/(kg·d)分3次套用;>2000g:日齡為0~7d,75mg/(kg·d)分3次套用,>7d150mg/(kg·d)分4次套用,均用靜脈途徑。萬古黴素的劑量:孕37周以下早產兒每次15mg/kg每12hl次,足月兒每次10~15mg/kg,每8hl次均靜脈套用。療程為7~10d。亦可用第二代頭孢菌素如頭孢呋肟,劑量為50~100mg/(kg·d)分2次靜脈給藥。
(3)鏈球菌敗血症 B組鏈球菌敗血症早期的臨床表現和新生兒呼吸窘迫綜合徵相類似,不易區別,治療上用大劑量青黴素20萬~40萬U/(kg·d)分2~3次靜脈給藥。(4)厭氧菌敗血症 近年來出現新生兒厭氧菌感染在逐漸增多,常見於胎膜早破,手術後併發症。治療上以甲硝唑(滅滴靈)為首選藥物。劑量:日齡≤7d15mg/(kg·d)分2次靜脈套用。>7d30mg/(kg·d)分2~3次靜脈給藥。治療療程為7~10d。
(5)際內感染所致敗血症 住院後有入侵式治療(臍靜脈插管、氣管插管等)長期套用廣譜抗生素、病房擁擠等都易發生院內感染。凝固酶陰性葡萄球菌引起的院內感染敗血症應選用萬古黴素,劑量同上所述,療程為7~10d。
革蘭陽性細菌引起的院內感染敗血症選用氨基糖甙類抗生素、如慶大黴素,劑量同上。但慶大黴素的耐藥性很普遍,而丁胺卡那黴素的耐藥性較低,常被選用。丁胺卡那黴素劑量:1500g2500g:20mg/(kg·d)分為12hl次,靜脈給藥。由於氨基糖甙類抗生素共同的副作用是有耳毒作用和腎臟毒性作用。因此需監測血清藥物濃度。
2、一般治療 注意保暖,維持水、電解質平衡及補充熱卡,及時糾正酸中毒及缺氧,局部感染灶如臍部及皮膚的處理等。
3、對症治療 有抽痙時用鎮靜止痙藥,有黃疸給於照藍光治療,有腦水腫及時給於降顱壓處理。
4、支持治療 少量多次輸血或輸血漿以增加機體的抵抗力。
5、免疫療法 新生兒出生時免疫系統發育不完善,特別是低出生體重兒更明顯,生後對各種抗原的刺激反應不敏感,感染後更削弱了自身免疫力。因此免疫治療可提高新生兒的免疫力,增強抗感染能力。
(1)免疫球蛋白治療 早產兒因免疫球蛋白水平低,生後極易發生低免疫球蛋白血症而致嚴重感染,敗血症的發生率和病死率均較成熟新生兒為高,足月兒雖無明顯的低免疫球蛋白血症,但也可因母體產生的免疫球蛋白缺乏某些特異性抗體如大腸桿菌、沙門菌抗體而不能控制這類感染。靜脈用丙種球蛋白含有大量免疫球蛋白和特異型抗體,因此可用於敗血症的輔助治療。資料推薦劑量:每次0.2~0.5g/kg每周1次共用4周。
(2)白細胞的輸入 重症敗血症患兒,若血中中性粒細胞數降低而骨髓儲備白細胞又不能補充粒細胞的缺乏時,輸入從正常成人血液中分離出來的多形核白細胞,可增強白細胞對病菌的吞噬功能和殺菌活性,從而降低病死率。
(3)交換輸血 重症敗血症患兒可通過換血除去血液中的細菌、毒素和酸性代謝產物;清除異常血凝物質,糾正異常血凝過程,供給大量新生兒所缺乏的抗體、補體以及吞噬細胞等,增強機體的抵抗力。交換輸血主張用新鮮全血,換血量為160ml/kg,但要注意換血後可能發生的併發症如電解質平衡紊亂、感染、移植性抗宿主反應等。換血療法適應於經抗感生素治療無效的重症新生兒敗血症。
敗血征的治療主要是抗菌療法,可先用兩種抗菌素,如耐酶青黴素加第三代頭孢菌素,待病原明確、藥敏結果出來後可停用一種,再根據藥敏結果選用敏感抗生素。一般療程7-10天,應靜脈用藥。
還要加強支持療法,靜脈補液糾正酸中毒及電解質紊亂,注意保暖,糾正缺氧;靜脈注射免疫球蛋白可提高免疫力,是近年來廣泛推薦的有效的治療方法。
鑑別
本病需與新生兒顱內出血相鑑別。新生兒顱內出血是新生兒期常見的嚴重疾患,主要表現為硬腦膜下出血、蛛網膜下出血、腦室周圍一腦室內出血、腦實質出血、小腦出血及混合性出血。
預防
 新生兒敗血症
新生兒敗血症預防新生兒敗血症要注意圍產期保健,積極防治孕婦感染,以防胎兒在宮內感染;在分娩過程中應嚴格執行無菌操作,對產房環境、搶救設備、復甦器械等要嚴格消毒;對早期破水、產程太長、宮內窒息的新生兒,出生後應進行預防性治療;做新生兒護理工作,應特別注意保護好皮膚、黏膜、臍部免受感染或損傷,並應嚴格執行消毒隔離制度。
此外,還要注意觀察新生兒面色、吮奶、精神狀況及體溫變化,保持口腔、臍部皮膚黏膜的清潔,如有感染性病灶,應及時處理。
併發症
新生兒敗血症最易並發化膿性腦膜炎,有時神經系統症狀並不明顯,但已並發此症。因此要提高警惕,及早作腦脊液檢查。其次易發生的併發症是肺炎或肺膿腫,出現呼吸系統症狀。其他遷移性病灶如蜂窩組織炎、骨髓炎和腎盂腎炎也偶可發生。
新生兒及兒童疾病
| 孩子是未來的希望,他們成長的腳步是父輩殷切關注的,一旦有個頭疼發熱就是揪緊了父母的心。了解新生兒和兒童常見疾病,安心陪伴孩子健康成長。 |
醫學疾病—兒科
| 小兒不同於成人,不論在解剖、生理、病理、免疫等方面,或是在疾病的生生,發展、臨床表現以及診斷、防治等方面,都有許多與成人不同的特點。且隨著年齡的增長,按一定的規律不斷地變化,是一個動態的過程。兒科疾病有很多種,本任務包含兒科57種疾病,是兒科大部分疾病。 |

